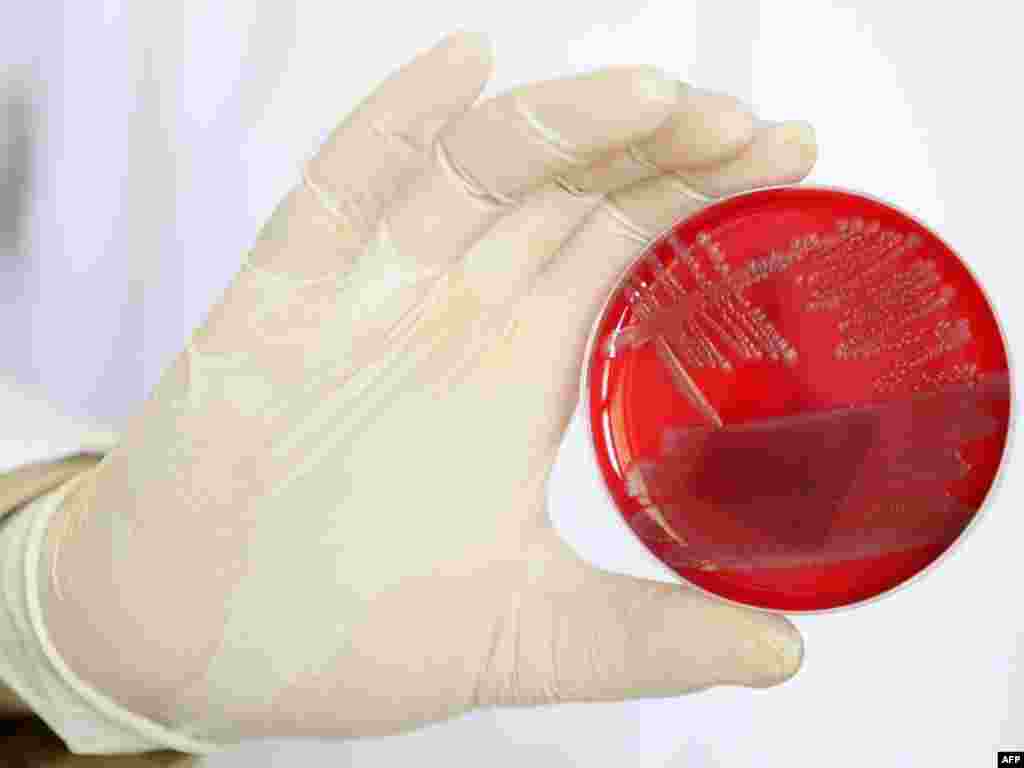
Європейські споживачі мають панічний страх перед вбивчою бактерією, що вже забрала життя 16 осіб. Попередні аналізи німецьких експертів вказували на те, що джерело зараження – іспанські огірки. Пізніше це твердження визнали помилкою, хоча криза призвела до багатомільйонних збитків фермерів Іспанії, Нідерландів та інших країн-експортерів. Тим часом, справжня причина поширення бактерії залишається загадкою. Photo by AFP

Антиурядові протести у Росії та Ємені; у Києві намагаються зберегти українські школи та незалежні медіа; Європа боїться нової бактерії; китайські хакери атакували Google; білоруський спецназ інтенсивно тренується; Ратко Младич вперше постав перед Міжнародним трибуналом у Гаазі
Тиждень у фотографіях: 30 травня – 3 червня

1
Поліція не дозволила провести в Москві та Петербурзі несанкціоновані акції на захист свободи зібрань, 31 травня.
Photo by Alexander Demianchuk for Reuters
Photo by Alexander Demianchuk for Reuters

2
Акція протесту FEMEN проти сурогатного материнства в Україні, Київ, 31 травня.
Photo by Gleb Garanich for Reuters
Photo by Gleb Garanich for Reuters

3
Акція проти русифікації українських шкіл та дитсадків у Києві, 1 червня.
Photo by Ukrainian Foto
Photo by Ukrainian Foto

4
Пуштунська дівчинка визирає із власного двору, Пешвар, Північний Пакистан, 1 червня.
Photo by Fayaz Aziz for Reuters
Photo by Fayaz Aziz for Reuters

5
У столиці Ємену Сані понад 40 осіб загинуло внаслідок сутичок між урядовими силами та прихильниками опозиції. Зіткнення між опозицією та прихильниками президента країни Алі Абдалли Салеха активізувалися у Сані у вівторок.
Photo by Mohammed Huwais for AFP
Photo by Mohammed Huwais for AFP

6
Тренування білоруського спецназу, 1 червня.
Photo by Vasily Fedosenko for Reuters
Photo by Vasily Fedosenko for Reuters

7
Хакери з Китаю зламали сотні електронних поштових скриньок сервісу Gmail, 2 червня. Про це заявили в компанії Google, якій належить цей сервіс. Атаки зазнали скриньки американських високопосадовців, військових і журналістів. Google не повідомляє, проти кого конкретно діяли хакери і чи була в зламаних скриньках конфіденційна інформація. Китай заперечує причетність до кібершпигунства в Google.
Photo by Jason Lee for Reuters
Photo by Jason Lee for Reuters
8
Європейські споживачі мають панічний страх перед вбивчою бактерією, що вже забрала життя 16 осіб. Попередні аналізи німецьких експертів вказували на те, що джерело зараження – іспанські огірки. Пізніше це твердження визнали помилкою, хоча криза призвела до багатомільйонних збитків фермерів Іспанії, Нідерландів та інших країн-експортерів. Тим часом, справжня причина поширення бактерії залишається загадкою.
Photo by AFP
Photo by AFP

9
У російському регіоні Удмуртія з пізнього вечора четверга триває пожежа і вибухи на складах боєприпасів. Це призвело до евакуації близько 28 тисяч осіб із 20-кілометрової зони навколо складів.

10
На Чернігівщині під час акції «Журналісти захищають Батьківщину» відбулися змагання між підрозділом журналістів і взводом вояків-контрактників, 2 червня.
Photo by Ukrainian Foto
Photo by Ukrainian Foto

11
Колишній генерал армії боснійських сербів Ратко Младич вперше постав перед Міжнародним трибуналом у Гаазі, 3 червня. Міжнародний трибунал з колишньої Югославії звинувачує його у воєнних злочинах і геноциді.
Photo by Dado Ruvic for Reuters
Photo by Dado Ruvic for Reuters

12
Учасники акції «Опір цензурі» біля Адміністрації Президента вимагають припинити тиск на українські медіа, Київ, 3 червня.
Photo by Sergiy Svitlytskyi for Ukrainian Foto
Photo by Sergiy Svitlytskyi for Ukrainian Foto




